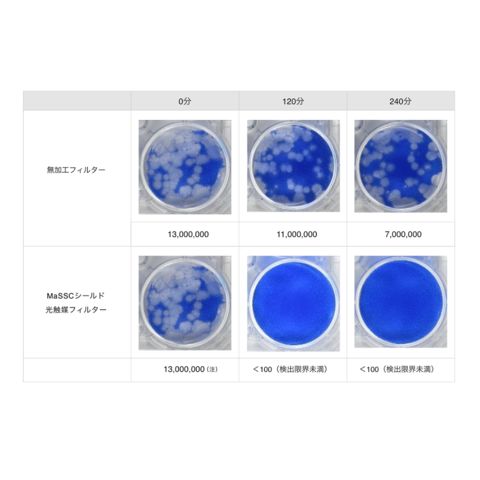

6/26
時点_ポイント最大10倍
光除菌空気清浄機 ブルーデオ M型 28畳 MC-M102 【直送品】 返品・キャンセル・他商品と同時購入は不可
販売価格
132,000
円 (税込)
送料無料
- 出荷目安:
- 通常:3-7営業日 発送目安
たまるdポイント(通常) 1,200
+キャンペーンポイント(期間・用途限定) 最大9倍
※たまるdポイントはポイント支払を除く商品代金(税抜)の1%です。
※表示倍率は各キャンペーンの適用条件を全て満たした場合の最大倍率です。
各キャンペーンの適用状況によっては、ポイントの進呈数・付与倍率が最大倍率より少なくなる場合がございます。
dカードでお支払ならポイント3倍
各キャンペーンの適用状況によっては、ポイントの進呈数・付与倍率が最大倍率より少なくなる場合がございます。
- 商品情報
- レビュー
 商品説明
商品説明臭い、花粉、ウイルス対策、これ1台!
●リビングや会議室など広い空間の空気を、パワフルに消臭・除菌します。●一台で約28畳分の部屋を消臭除菌いたします。だから密室になりがちな会議室などもカバーすることが可能です。●お客様が安心してご利用できるための1つの提案です。空間を消臭除菌し、安心安全でリラックスできる空間を提供いたします。●一般的な空気清浄機のフィルターは、菌やウイルス、臭いとなるガス成分を「吸着」させる方式ですが、ブルーデオM型は光除菌フィルターで「元から分解して除去」します。●オゾン、イオン、次亜塩素酸などの放出はゼロ。有害因子を本体内部の光除菌フィルター上で分解・除去してキレイな空気でお部屋を満たします。●コンセントを差して、電源ボタンを押すだけ。
ひとつのボタンで、電源ON/OFF、及び風量切り替えができます。●HEPAフィルターを搭載で集塵力が大幅にアップ。推奨床面積は約28畳に対応し、大空間を消臭・除菌します。
【仕様】
●サイズ:幅300×奥行320×高さ700mm●重量:約7.6kg●電源:100V●推奨床面積:約28畳
サイズ
サイズ:幅300×奥行320×高さ700mm
カラー
ホワイト
問い合わせ先
マスクフジコー 問合せ:0120-80-2450 受付時間:9~17時 (平日のみ)
メーカー名(製造販売会社)
マスクフジコー
ブランド名
ブルーデオ
原産国
日本
広告文責
株式会社サンドラッグ/電話番号:0120-009-368
JAN
4562352860054
※パッケージ・デザイン・内容等は、リニューアルにより予告なしに変更される場合がありますので、予めご了承ください。
※お届け地域によっては、表記されている日数よりもお届けにお時間を頂く場合がございます。
空気 清浄機 除菌 光 消臭 リビング 会議室 美容室 店 ペット 花粉